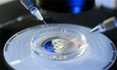

「促排卵食物」促卵泡激素4.44是不是正常
时间:2025-10-22 10:03 浏览次数:614
促排卵食物?促卵泡激素4.44是不是正常?黑豆等豆制品都对促排卵有一定的效果,因为大豆中含有大量大豆异黄酮,是无副作用的植物雌激素,补充雌激素效果很好,而且含有植物蛋白,纤维素等营养成份,可以长期吃。

年轻夫妻们在经历了婚姻的甜蜜后,都会想要个孩子来见证彼此间的爱情,而我们现在的社会都讲究优生优育,很多夫妻都会努力调养好身体,调整好生活作息,从容地准备迎接自己的孩子。那么,在备孕过程中,女性能否顺利排卵,就显得至关重要。
现代人们生活节奏紧张,工作压力大,很多女性结婚后,需要兼顾家庭和事业,往往身心俱疲,如果不能保证心情舒畅和营养摄入均衡,很可能会造成身体上的不适,甚至一月一次的排卵,也会造成不利的影响。如果排卵不好或者无排卵,不仅对女性身体不利,还有可能导致不孕,因此,有要孩子打算的朋友们,一定要细心关注自己的排卵是否正常,在日常生活中可以通过促排卵的食物来改善排卵状况。
女性朋友们在平时的饮食中,可以适当添加豆类、栗子、南瓜、橘子等食物;也可以多饮用炖牛肉、鸡肉的高汤等,另外常吃以下食物也可以促排卵。
枸杞羊肾粥:枸杞子500克,羊肾1对,羊肉250克,粳米250克,葱白5克。将羊肾洗净,剁成末,枸杞子洗净,全部放入沙锅内,熬粥,待肉熟、米烂时即成。食肉喝粥。每天2次,早晚空腹温服。
莲子猪肚:莲子、猪肚各适量。将猪肚洗净,纳入莲子,两端扎紧,置锅中炖烂,加入食盐适量及味精随餐食用。
卵泡刺激素是性激素六项的中的一样。女性月经期间可以通过检测卵泡刺激素来了解卵泡的成熟度,可以使卵泡更好地发育,如果卵泡发育的不好,很容易就会影响到女性孕育功能,那么促卵泡激素4.44是不是正常呢?
促卵泡生成激素(FSH):促进卵巢的卵泡发育和成熟。正常值:在排卵前期为1.5~10mIU/ml,排卵期为8~20mIU/ml,排卵后期为2~10mIU/ml。泡刺激素(简称FSH,也叫卵泡生成素)。FSH和LH与生殖腺组织的生长和生殖活性的控制密切相关,在绝经期、卵巢切除术后及早熟性卵巢衰竭中FSH上升,FSH与LH之间及FSH与雌激素之间的异常关系与神经性厌食和多囊卵巢病有关。在随机测定FSH浓度超过40miu/ml时提示卵巢衰退。在男性,输精管生长以及保持精子产生往往受FSH的调节,无精症和少精症男性的FSH水平通常是升高的,FSH升高,同时还见于原发性睾丸衰竭和精细管发育不全、饥饿、肾衰竭、甲亢和肝硬化等;而睾丸肿瘤一般FSH浓度降低。
增高:见于原发性闭经、原发性性功能减退早期、垂体前叶功能亢进、睾丸精原细胞瘤、Turner综合征、klinefelter综合征等以及摄入氯米芬、左旋多巴等药物;减低:见于雌激素或孕酮治疗继发性性腺功能减退、希恩综合征(又称席汉综合征)、晚期垂体功能低下以及摄入口服避孕药、性激素等药物;促卵泡成熟激素的正常值是根据患者的年龄、月经周期等有所变化的。一般卵泡期在1-9U/L。建议如果有月经失调的表现,要到正规医院妇科就诊,在医生指导下进行相应的检查,然后根据检查情况,有针对性的进行治疗。
促卵泡生成激素想要生育,女性必须要有畅通无阻的输卵管,正常健康成熟的卵子,并且要能正常的排卵,同时子宫环境要适合胎儿生长,内膜的厚度正常(0.8-1.0cm),女方的内分泌正常才能维持胎儿的正常生长和发育,检查一下排卵的情况,明确是激素水平导致的,就可以再医生的指导下用药调理。
相关文章

6个月代生宝宝腹泻2天,大便有奶瓣带粘液是奶粉喂养过度吗?

北京代怀咨询男孩,北京试管婴儿哪家技术牛?附项目费用清单!

取卵后第二次月经推迟

沈阳助孕多少钱,2026沈阳国内代生代怀费用预估!

深入剖析子宫内膜异位症:四大分型及诊断方法详解

盆腔炎:认识这种疾病及其治疗方法的指南
最新资讯

月经推迟20天有点淡淡的血
代孕卵子真实性
2025-10-24

子宫后位去柬埔寨做试管能成功吗,子宫后位对试管胚胎移植的影响详解
代孕卵子真实性
2025-10-22
月经推迟5天能验孕吗
代孕卵子真实性
2025-10-22

「促排卵食物」促卵泡激素4.44是不是正常
代孕卵子真实性
2025-10-22

排卵后21天才测出怀孕正常吗
代孕卵子真实性
2025-10-22

不孕不育治疗取卵后出现腹水是什么原因
代孕卵子真实性
2025-10-22
热门资讯

子宫肌瘤患者要警惕!饮食不当会导致病情恶化,快来看看吧!
代孕卵子真实性
2024-07-26

警惕:白带异常的信号你看得懂吗?掌握四个方法,让你从容应对!
代孕卵子真实性
2024-04-25

哪些孕妇容易发生宫外孕
代孕卵子真实性
2024-06-08

北京供卵不排队医院_北京家圆医院是正规的吗
代孕卵子真实性
2024-05-15

北京代孕产子中心,北京代代助孕
代孕卵子真实性
2024-03-14

取卵后第二次月经推迟
代孕卵子真实性
2025-04-25